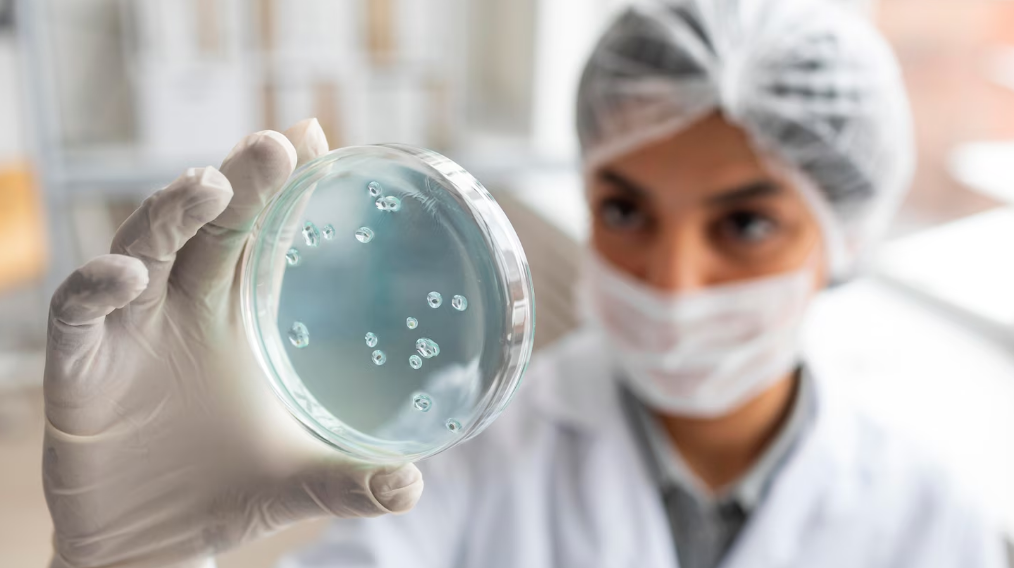
Técnica analisando culturas microbianas em laboratório de biotecnologia farmacêutica

Se você quer saber mais sobre a produção de biofármacos e seus impactos na vida de pacientes e profissionais da saúde, está no lugar certo!
Neste artigo, você vai entender como moléculas como a insulina humana são fabricadas, quais desafios a indústria nacional enfrenta e como se especializar para atuar nesse campo que salva milhões de vidas.
Como é feito o controle de qualidade?
Quais profissionais podem trabalhar nessa produção?
O que são biofármacos?
Biofármacos são medicamentos produzidos a partir de organismos vivos, como bactérias, leveduras e células animais, ou componentes biológicos, como proteínas e DNA.
Os biofármacos, como o infliximabe, eritropoetina, trastuzumabe e a vacina da hepatite B, são produzidos por organismos vivos, como células de hamster (CHO), células ovarianas de inseto e leveduras Pichia pastoris.
Eles têm indicações específicas, como tratamento de artrite reumatoide, anemia crônica, câncer de mama HER2+ e prevenção de hepatite B.
Por outro lado, os fármacos sintéticos são criados através de síntese química em laboratório. Eles são pequenas moléculas com estrutura simples e replicável. A regulação desses medicamentos é mais simples e baseada em bioequivalência.
Já os biofármacos possuem moléculas grandes e complexas, o que as torna mais difíceis de replicar quimicamente. A regulação desses medicamentos é mais rigorosa, exigindo testes clínicos para garantir sua eficácia e segurança, especialmente no caso dos biossimilares.
Outro exemplo são os anticorpos monoclonais, usados no tratamento de câncer e doenças autoimunes, como o adalimumabe, utilizado para artrite reumatoide. Além disso, vacinas de mRNA, como as da Pfizer/BioNTech contra a COVID-19, também se enquadram como biofármacos.
Em 2023, o mercado global de biofármacos ultrapassou US$ 570 bilhões, impulsionado por terapias inovadoras como anticorpos monoclonais e vacinas de mRNA.
“The global biopharmaceuticals market was valued at USD 616.94 billion in 2024.” (O mercado global de biofármacos foi avaliado em US$ 616,94 bilhões em 2024).
Fonte: Biopharmaceuticals Market
Biofármacos, fármacos sintéticos e biossimilares |
||
| Tipo de medicamento | Origem / estrutura | Regulação e características |
|---|---|---|
| Biofármacos | Produzidos por organismos vivos; moléculas grandes e complexas. | Regulação rigorosa, exigindo testes clínicos para comprovar segurança e eficácia. |
| Fármacos sintéticos | Obtidos por síntese química em laboratório; pequenas moléculas. | Regulação baseada em bioequivalência; estrutura simples e replicável. |
| Biossimilares | Versões similares de biofármacos de referência. | Seguem critérios rígidos de comparabilidade e tendem a ser mais baratos que o original. |
Como são produzidos?
No Brasil, cerca de 80% dos biofármacos consumidos são produzidos internamente. Ou seja, é um setor que está abrindo oportunidades para profissionais da saúde que queiram migrar para áreas como biotecnologia e microbiologia.
A produção de biofármacos envolve quatro etapas principais. A primeira etapa é a engenharia genética, na qual o gene humano que codifica a proteína desejada, como a insulina, é inserido em microrganismos.
Esses microrganismos, geralmente bactérias ou leveduras, passam a produzir a proteína humana.
Em seguida, ocorre a etapa de fermentação, onde os microrganismos geneticamente modificados são cultivados em biorreatores de grande escala. Esse processo permite a multiplicação celular e a produção em massa da proteína desejada.
A terceira etapa é a purificação, na qual a proteína é separada dos demais componentes celulares e impurezas através de técnicas como cromatografia e ultrafiltração. Esse processo é essencial para garantir a pureza e a segurança do biofármaco.
Por fim, a etapa de formulação envolve a adição de estabilizadores à proteína purificada para manter sua estabilidade e eficácia. O biofármaco é então envasado em seringas ou frascos, prontos para distribuição e uso médico.
Leia mais: Absorção de fármacos: Conhecimentos essenciais para o Farmacêutico Hospitalar
“Medicamentos biológicos são produzidos utilizando-se a tecnologia do DNA recombinante.”
Fonte: Biofármacos no Brasil: uma revisão do processo de regulamentação
Como é feito o controle de qualidade?
A Agência Nacional de Vigilância Sanitária (Anvisa) exige testes rigorosos para garantir segurança e eficácia. Assim, a análise de pureza utiliza HPLC e espectrometria de massa para verificar a ausência de contaminantes.
A potência dos medicamentos é avaliada por meio de testes in vitro, comparando a atividade biológica com a do medicamento original. A estabilidade é validada através do armazenamento em condições extremas para confirmar o prazo de validade.
A Agência Nacional de Vigilância Sanitária (Anvisa) exige testes rigorosos para garantir segurança e eficácia.
Quais profissionais podem trabalhar nessa produção?
Biotecnólogos projetam microrganismos geneticamente modificados para diversas aplicações, como produção de biofármacos, biocombustíveis e outras substâncias de interesse industrial. Farmacêuticos industriais supervisionam os processos de purificação dos produtos, garantindo a qualidade e a segurança do que é produzido.
Microbiologistas desempenham um papel importante ao monitorar a contaminação em biorreatores, onde microrganismos são cultivados para produção em larga escala. Eles garantem que as condições estejam ideais para o crescimento dos microrganismos e que não haja contaminação que possa comprometer o processo.
Engenheiros bioquímicos são responsáveis por otimizar o escalonamento da produção, ou seja, aumentar a produção de uma substância de maneira eficiente e econômica. Eles trabalham para resolver problemas que podem surgir quando processos de laboratório são transferidos para a produção em larga escala.
Os salários para esses profissionais variam consideravelmente:
- Analistas de controle de qualidade: são responsáveis por garantir que todos os produtos atendam aos padrões de qualidade exigidos. Seus salários variam entre R$ 5.000,00 e R$ 8.000,00 por mês;
- Especialistas em fermentação: focam no processo de fermentação, essencial para a produção de muitos biofármacos e produtos químicos. Podem ganhar entre R$ 10.000,00 e R$ 18.000,00 mensais;
- Gerentes de P&D (Pesquisa e Desenvolvimento): lideram equipes que desenvolvem novos produtos e processos. Em multinacionais, podem receber até R$ 25.000,00 por mês.
Esses salários refletem a alta demanda por profissionais qualificados em biotecnologia e a importância dessas funções para o sucesso das operações industriais.
Impacto econômico dos biofármacos
A redução de custos é um benefício significativo dos biossimilares, que são 30% mais baratos do que os medicamentos originais.
Isso resulta em uma economia de até R$ 2 bilhões por ano para o Sistema Único de Saúde (SUS), permitindo que mais recursos sejam alocados para outras áreas da saúde pública, melhorando o atendimento e acesso aos tratamentos.
O setor de biotecnologia emprega cerca de 120 mil pessoas no Brasil, com projeção de crescimento para 300 mil até 2030. Estima-se que 25% dessas vagas estejam diretamente ligadas à produção de biofármacos.
Esse aumento na oferta de empregos beneficia a economia do país, proporcionando oportunidades de carreira e desenvolvimento profissional para muitos brasileiros.
“medicamentos biológicos e biossimilares – fármacos de última geração destinados ao tratamento de enfermidades complexas como câncer, artrite reumatoide e outras doenças autoimunes.”
Fonte: Foco nos biofármacos
Inovação em Biofármacos
Existem diversos tipos de tecnologias inovadoras na indústria de biofármacos! A terapia gênica utiliza vírus modificados para entregar genes terapêuticos às células do paciente. Um exemplo disso é o Zolgensma®, usado no tratamento de atrofia muscular espinhal.
Esses vírus atuam como veículos que transportam os genes corretivos diretamente para as células afetadas, permitindo a produção de proteínas funcionais que podem corrigir a deficiência genética.
A tecnologia CRISPR, por sua vez, permite a edição genética precisa de microrganismos. Isso significa que podemos modificar os genes desses organismos para que produzam fármacos mais eficazes e personalizados. Assim, a CRISPR possibilita mudanças rápidas e específicas no DNA.
A impressão 3D de proteínas é uma inovação que possibilita a criação de anticorpos sob demanda para tratamentos personalizados de câncer. Esta técnica permite a fabricação de proteínas complexas e específicas que podem atacar células cancerígenas de maneira eficiente e personalizada.
Conclusão
A produção de biofármacos é um campo desafiador, mas repleto de oportunidades se você quer unir saúde e tecnologia. Com investimentos em inovação e formação de profissionais, o Brasil pode reduzir sua dependência de importações e tornar terapias de ponta acessíveis a milhões.
Se você é um profissional da saúde, invista em uma pós-graduação em biotecnologia ou farmácia industrial e posicione-se nesse mercado em ascensão. O futuro da medicina está nas moléculas que você pode ajudar a criar.
FAQ
-
O que diferencia biofármacos de medicamentos sintéticos?
Biofármacos são produzidos a partir de organismos vivos e possuem estruturas complexas, enquanto os sintéticos são obtidos por síntese química, com moléculas menores e mais simples.
-
Quais áreas profissionais podem se beneficiar de uma pós-graduação em biofármacos?
Biotecnologia, microbiologia, farmácia industrial, controle de qualidade, fermentação e pesquisa e desenvolvimento estão entre as áreas que mais demandam especialistas em biofármacos.
-
Os biossimilares realmente reduzem custos para o sistema de saúde?
Sim. Como tendem a ser cerca de 30% mais baratos do que o medicamento original, contribuem para economias significativas em sistemas públicos como o SUS.






